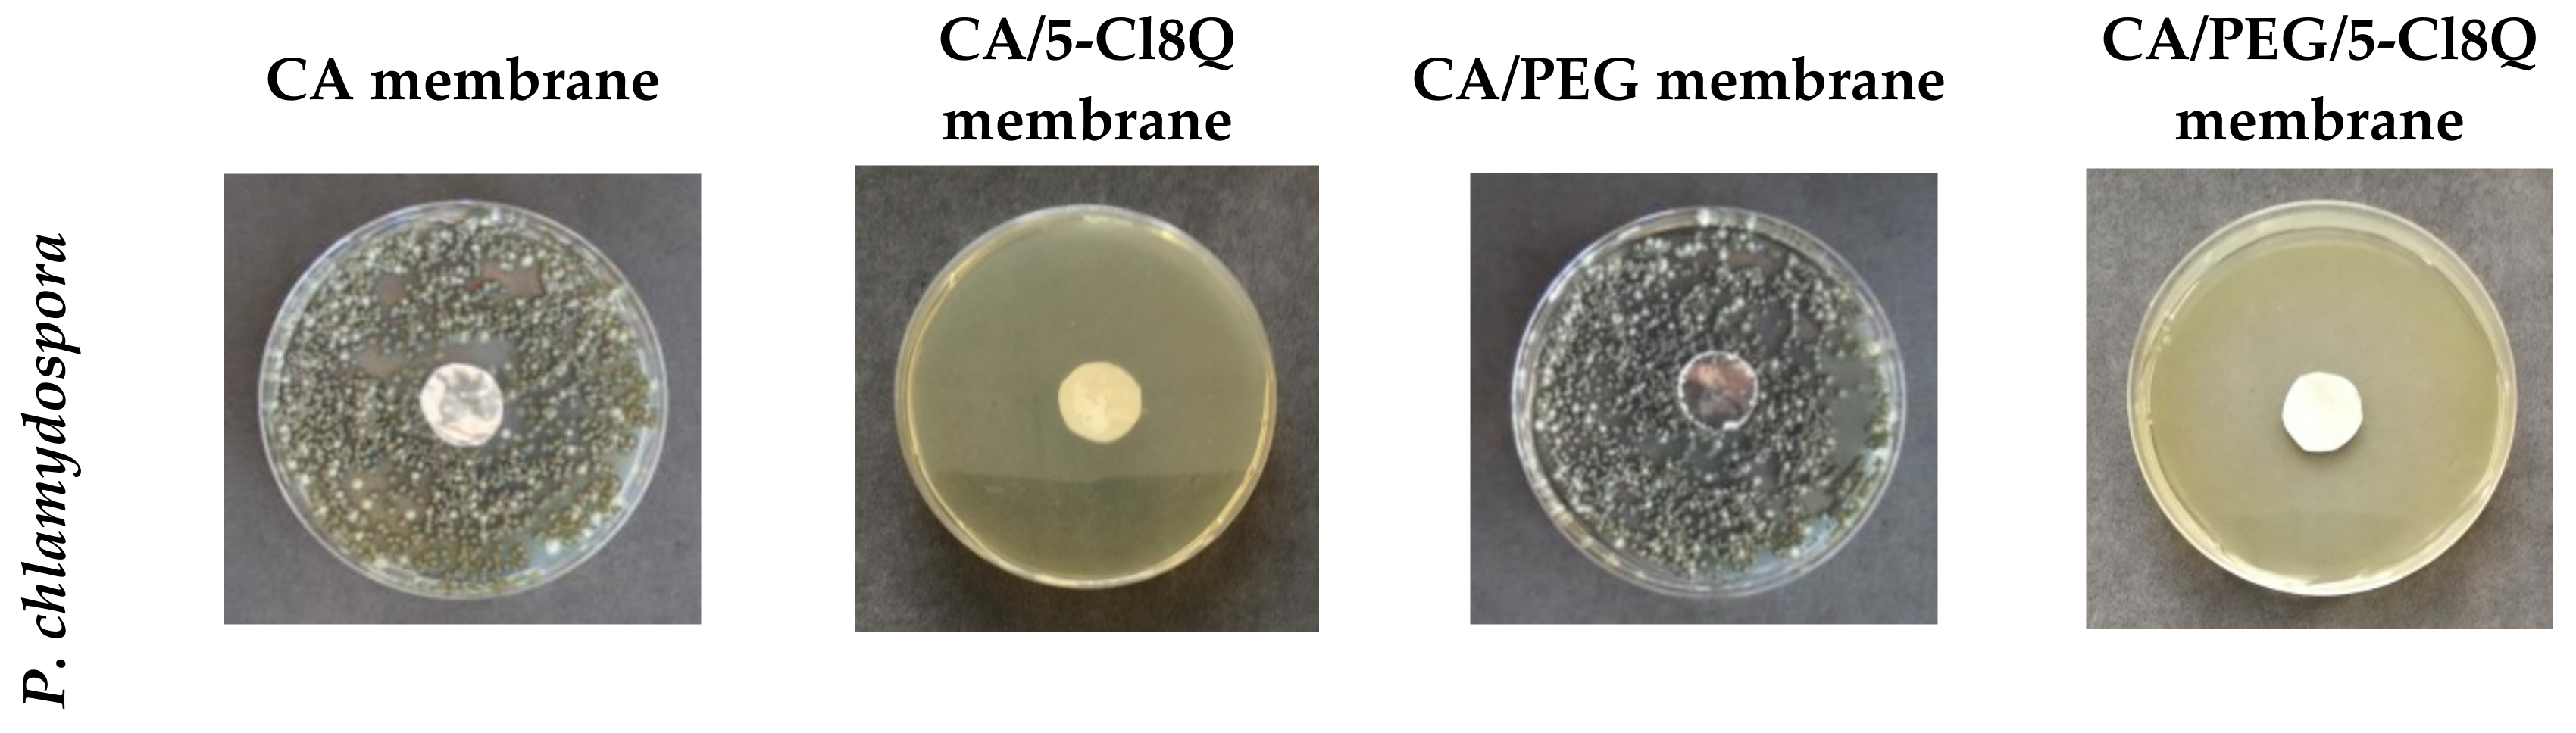
Polymers 11 01617 g006a
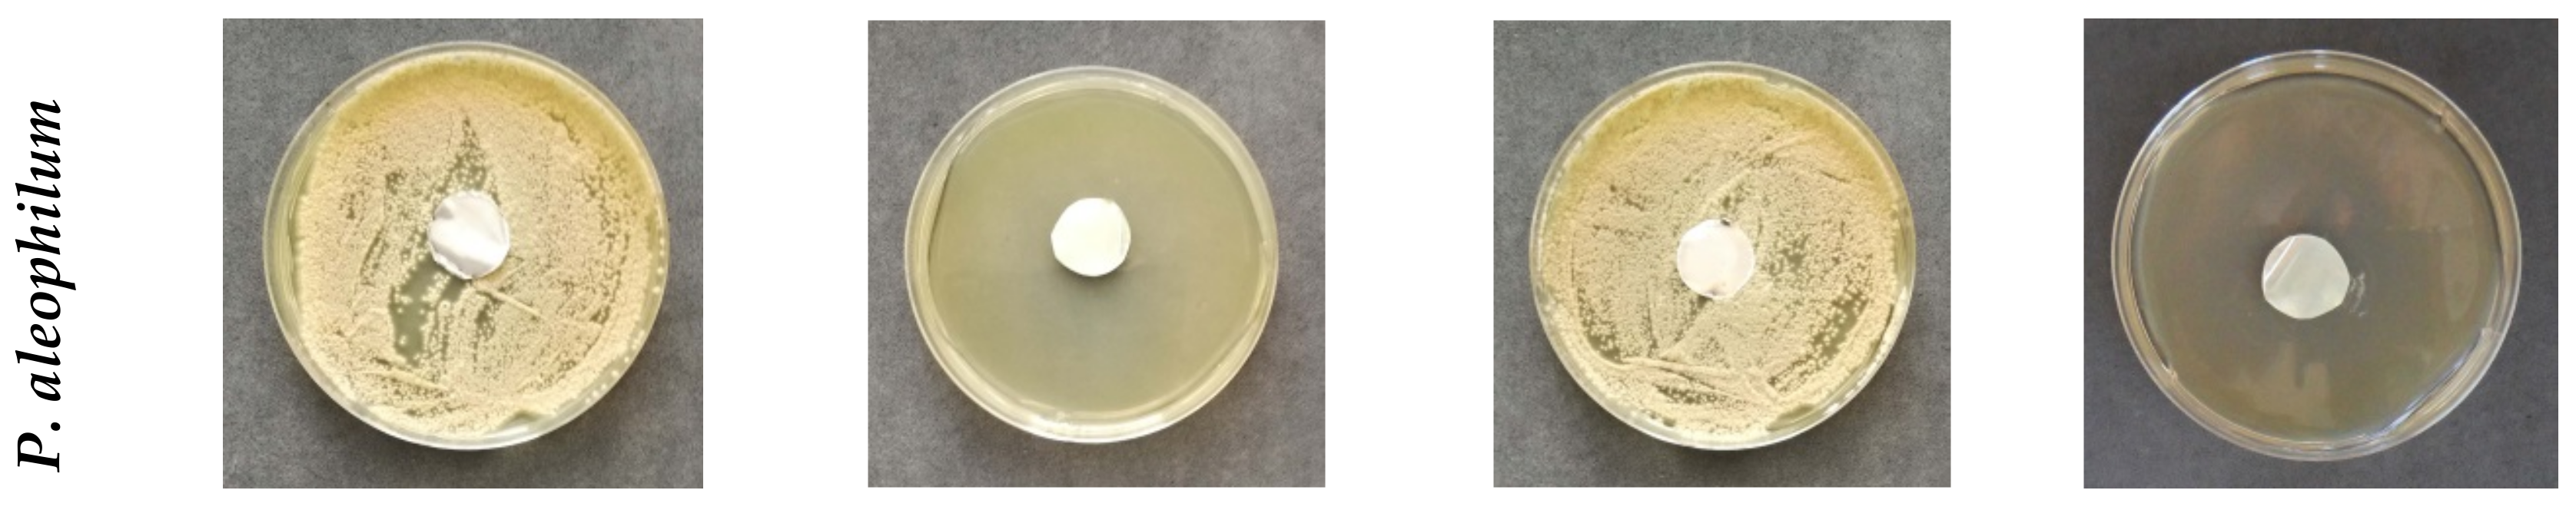
Polymers 11 01617 g006b

1. Introduction
Electrospinning is currently regarded as one of the most promising nanotechnologies for the preparation of fibers with micro- and nanoscale diameters and a large specific surface area, which is a prerequisite for the attainment of high effectiveness in a number of applications; e.g., medicine and agriculture [
1,
2].
Esca is grapevine trunk disease that causes dark red or yellow stripes on leaves, trunk damage and the sudden wilting of the entire plant [
3,
4]. It is known that esca disease is caused mainly by the species
Phaeomoniella chlamydospora and
Phaeoacremonium aleophilum [
5,
6]. Over the last three decades, the impact of esca disease has become a dramatic global threat to all vineries. The wounds formed during the pruning procedure on vines are considered to be one of the main entrances for the penetration of
Phaeomoniella chlamydospora and
Phaeoacremonium aleophilum spores in grapevines. To date, sodium arsenite is the only known and effective agent for fighting esca; however, arsenic and its compounds have recently been classified as carcinogenic and their use has been disallowed. Thus, in practice, there are no known curative approaches for fighting esca directly. This requires the development of new approaches to fight esca in order to prevent the loss of vineyards and losses for the wine industry.
Materials consisting of rayon membranes on which electrospun nanofibers of soy protein/polyvinyl alcohol and soy protein/polycaprolactone are deposited have been proposed for physically blocking fungal spore penetration [
7]. It has been reported that the physical blocking is insufficient, and the inclusion of an antifungal component has been put forward [
8]. The proposed materials consist of lactide/glycolide copolymer and poly(butyleneadipate-
co-terephthalate) blended with a specially synthesized antifungal polymer–polyhexamethylene guanidine. In our study, we propose the facile preparation of fibrous membranes containing an easily available and efficient antifungal compound, 8-hydroxyquinoline derivative, for active protection against spore penetration and plant infection. Moreover, the electrospun micro- and nanostructured membranes allow air and moisture permeability and allow the plant wound to “breathe”.
8-Hydroxyquinoline and its derivatives manifest antibacterial and antifungal activities [
9,
10] and are of low toxicity to humans [
11]. Moreover, we have recently shown that the combination of water-soluble polymers and 8-hydroxyquinoline derivatives results in the obtaining of a stable solutions with antifungal activity suitable for applications in agriculture. The minimum inhibitory concentration (MIC) values of 5-Cl8Q against
P. chlamydospora and
P. aleophilum were found to be 0.75 μg/mL for both strains [
12].
Cellulose acetate (CA) is one of the most important esters of cellulose. The advantages of CA are its low cost, easily feasible production and wide variety of applications [
13]. Recently, great attention has been paid to fibers from cellulose and cellulose derivatives due to their biodegradability and good mechanical and barrier properties [
14].
In the present study, a suitable combination of selected polymers (cellulose acetate and polyethylene glycol) with 5-Cl8Q is suggested by using an effective method—electrospinning—that will enable the creation of fibrous polymer membranes with antifungal activity.
The obtained materials were characterized by SEM, FTIR, UV-Vis, water contact angle measurements and mechanical tests. The possibility of modulating the 5-Cl8Q release profile by the appropriate selection of the composition of the polymer matrix was shown. The effect of the fibrous membranes on the biological behavior upon contact with P. chlamydospora and P. aleophilum was also assessed.
2. Materials and Methods
2.1. Materials
Cellulose acetate (CA, Aldrich, St. Louis, MO, USA) with at 30,000 g/mol and 39.8 wt% of degree of substitution in acetyl content, polyethylene glycol (PEG, Fluka, Buchs, Switzerland) with relative molecular mass (Mr) 1900–2000 g/mol, polyethylene oxide (PEO, Serva, Heidelberg, Germany) with Mr ca. 100,000 g/mol and 5-chloro-8-hydroxyquinolinol (5-Cl8Q, Sigma-Aldrich, Buchs, Switzerland) were used. Acetone (Sigma-Aldrich) of analytical grade of purity was used. Potato dextrose agar medium was purchased from Merck, Darmstadt, Germany. The disposable consumables were supplied by Orange Scientific, Braine-l’Alleud, Belgium.
2.2. Preparation of Fibrous Membranes by Electrospinning
Four types of fibrous membranes were prepared by electrospinning: Type 1: CA (control); type 2: CA/5-Cl8Q, Type 3: CA/PEG (control); and Type 4: CA/PEG/5-Cl8Q. For the preparation of membranes, the following spinning solutions were prepared in acetone/water at 80/20 v/v: (i) CA; (ii) CA/5-Cl8Q; (iii) CA/PEG; and (iv) CA/PEG/5-Cl8Q with a total polymer concentration of 10 wt% and 5-Cl8Q 10 wt.% with respect to total polymer weight.
The electrospinning set-up was composed of a custom-made high-voltage power supply (up to 30 kV), a grounded rotating drum collector, an infusion pump (NE-300 Just InfusionTM Syringe Pump, New Era Pump Systems Inc., New York, NY, USA) to deliver the spinning solution at a constant rate and a syringe equipped with a metal needle (gauge: 20GX1½″). Electrospinning was performed under the following conditions: a flow rate of 3.0 mL/h, voltage of 25 kV, needle tip-to-collector distance of 15 cm, collector rotating speed of 1000 rpm, a room temperature of 21 °C and a relative humidity of 50%.
2.3. Characterization of the Fibrous Membranes
The dynamic viscosity of the spinning solutions was measured using a Brookfield DV-II+ Pro programmable viscometer for the cone/plate option equipped with a sample thermostated cup and a cone spindle at 25 ± 0.1 °C.
The morphology of the fibrous membranes was analyzed by SEM. The samples were vacuum-coated with gold and observed by a Jeol JSM-5510 SEM (Tokyo, Japan). The average fiber diameter was estimated by ImageJ software [
15] by measuring at least 20 fibers from three different SEM micrographs for a total of 60 measurements, and their morphology was assessed, applying the criteria for the overall evaluation of electrospun materials as described in detail in [
16].
Attenuated total reflection Fourier-transform infrared (ATR-FTIR) spectra were recorded using an IRAffinity-1 spectrophotometer (Shimadzu Co., Kyoto, Japan) equipped with a MIRacle™ATR (diamond crystal, depth of penetration of the IR beam into the sample – about 2 μm) accessory (PIKE Technologies, Madison, WI, USA) in the range of 600–4000 cm−1 with a resolution of 4 cm−1. All spectra were corrected for H2O and CO2 using an IRsolution software program.
The static contact angle measurements of the membranes were taken using an Easy Drop DSA20E Krüss GmbH drop shape analysis system (Hamburg, Germany) at 20 ± 0.2 °C. A sessile drop of deionized water with a volume of 10 μL controlled by a computer dosing system was deposited onto the membranes (2 cm × 7 cm; cut in the direction of rotation of the collector). The contact angles were calculated by computer analysis of the acquired images of the droplet. The data were averaged from 20 measurements for each sample.
Mechanical properties were evaluated by tensile measurements performed on the fibrous membranes using a single column system for mechanical testing, INSTRON 3344, equipped with a loading cell 50 N and Bluehill universal software. The stretching rate was 10 mm/min, the initial length between the clamps was 40 mm and the room temperature was 21 °C. All samples were cut in the direction of collector rotation with dimensions of 20 × 60 mm and a thickness of ca. 200 µm. For the sake of statistical significance 10 specimens of each sample were tested, after which the average values of Young’s modulus, the ultimate stress and the maximum deformation at break were determined.
The 5-Cl8Q release was studied in vitro at 37 °C in acetate buffer (CH3COONa/CH3COOH) containing lactic acid (acetate buffer/lactic acid = 96/4 v/v) at pH 3 and an ionic strength of 0.1. 5-Cl8Q-containing nanofibrous membranes (4 mg) were immersed in 100 mL of buffer solution under stirring in a water bath (Julabo, Germany). The release kinetics was determined by withdrawing aliquots (2 mL) from the solution at determined time intervals, adding back the same amount of fresh buffer and recording the absorbance of the aliquots by a DU 800 UV–vis spectrophotometer (Beckman Coulter) at a wavelength of 255 nm. The amount of released 5-Cl8Q was calculated using calibration curves (correlation coefficient R = 0.999) for the membranes in acetate buffer/lactic acid = 96/4 v/v, pH = 3, at an ionic strength of 0.1. The data are average values from three measurements.
2.4. In Vitro Antifungal Assay
The antifungal activity of membranes was monitored against the fungi P. chlamydospora Centraalbureau voor Schimmelcultures (CBS) 239.74 and P. aleophilum CBS 631.94. P. chlamydospora CBS 239.74 and P. aleophilum CBS 631.94 were purchased from Westerdijk Fungal Biodiversity Institute, Utrecht, the Netherlands.
There are data in the literature showing that, under laboratory conditions,
P. chlamydospora and
P. aleophilum grow normally on potato dextrose agar [
17] and malt extract agar [
18]. In order to measure the zones of inhibition, in vitro studies were performed using potato dextrose agar medium (PDA, Merck, Darmstadt, Germany) for the fungal strains. The surface of the solid agar was inoculated with a suspension of fungi culture with a fungi concentration of 1 × 10
5 cells/mL, and on the surface of the agar in each Petri dish, one membrane was placed. The Petri dishes were incubated for 96 h for the
P. chlamydospora and
P. aleophilum at 28 °C, and subsequently the zones of inhibition around the disks were measured. The average diameters of the zones of inhibition were determined using the ImageJ software based on 15 measurements in 15 different directions for each zone.
4. Discussion
The schematic representation of the concept of this work is shown in
Figure 7. The research concept is based on the assumption that, by using the electrospinning method, it is possible to find an effective experimental approach to obtain innovative micro- and nanostructured polymer membranes with fungicidal activity against
P. chlamydospora and
P. aleophilum. Moreover, the so-called “active dressing” made of electrospun polymer membranes will not only be advantageous due to its fungicidal activity against some of esca‘s causes, but it will also allow the plant wound to “breathe”.
Combining the natural polymer CA and water-soluble polymer PEG in materials designed for biomedical and agricultural applications has attracted attention because CA and PEG are polymers which have low toxicity. Moreover, the incorporation of 5-Cl8Q would impart an antifungal activity to the prepared materials.
In the present study, the versatility of electrospinning was exploited in order to create innovative polymer membranes with fungicidal activity against two strains or ascomycete fungi—P. chlamydospora and P. aleophilum—associated with esca, which is the most devastating grapevine disease.
The study is focused on finding conditions for combining the properties of the polysaccharide derivative cellulose acetate [
24] and the polyethers PEG or PEO with a biologically active compound (5-Cl8Q). The incorporation of 5-Cl8Q in the polymer matrix is expected to impart antifungal activity to the obtained membranes. Moreover, PEG and PEO have been reported as solubilizing agents for poorly water-soluble drugs [
25] and will lead to the more rapid release of the biologically active compound.
The measurements of the spinning solution viscosity showed that the incorporation of PEG into the CA solution resulted in a viscosity decrease, which was due to the low molecular weight of this polymer. The incorporation of 5-Cl8Q in the solutions of CA and CA/PEG led to insignificant increases in dynamic viscosity values.
In the present study, we used SEM analysis to observe the morphology of the obtained membranes. SEM micrographs of the obtained electrospun CA fibers showed that they were defect-free. The incorporation of PEG in CA resulted in a decrease of the diameters of the obtained fibers compared to neat CA fibers. The observed effect may be explained by the decrease in the solution viscosity by adding a lower-molecular-weight polymer (PEG) to the spinning solution. Moreover, the addition of 5-Cl8Q to the spinning solutions resulted in a slight decrease of the fiber diameter; this decrease is in accordance with previous findings about fibrous materials prepared by the electrospinning of polymer solutions containing an ionogenic low-molecular-weight compound [
26,
27].
Fourier transform infrared spectroscopy (FTIR) is a reliable analytical tool for the identification of polymers and polymer samples and the quantification of components in polymer mixtures. In the present study, FTIR verified the presence of 5-Cl8Q in the electrospun membranes by the appearance of a new band characteristic of the quinoline ring.
Contact angle analysis was used to give an indication of the surface wettability depending on the composition of the prepared membranes. It was found that CA and CA/5-Cl8Q membranes were hydrophobic. The obtained values of the water contact angle of CA are in good agreement with the literature. There are reports revealing that CA electrospun fibers are hydrophobic and even superhydrophobic [
28]. This is explained by the increased surface roughness through electrospinning and the reduction of the surface energy after electrospinning. In the present study, a high contact angle for the CA/5-Cl8Q membrane was determined, indicating that the bioactive compound does not alter the contact angle values and that these membranes remain hydrophobic. This was expected because of the aromatic character of the bioactive compound and the presence of chlorine in its structure.
The most commonly used and feasible method for modulating the hydrophilic/hydrophobic surface properties is the blending of hydrophilic polymers with hydrophobic polymers [
29]. In the present study, we incorporate PEG to CA and CA/5-Cl8Q by blending in order to impart hydrophilicity and to ensure a more rapid release of the bioactive compound. As expected, the presence of the water-soluble polymer PEG in the membranes resulted in hydrophilization and a decrease of the water contact angle. The measured water contact angle values for CA/PEG and CA/PEG/5-Cl8Q membranes were 0°.
The mechanical properties of the electrospun fibrous materials depend on their composition, fiber diameters, fiber alignment, presence of defects, crystallinity degree, etc. [
30]. There are different approaches to enhancing the mechanical properties of the fibrous mats; for instance, it is possible to prepare fibrous materials with the desired strength by varying the weight ratios of the two polymers [
31] or by the interconnection of fibers [
30]. We have proved that an issue of great significance is the direction in which the test specimens are cut, whether parallel (0°) or at a definite angle with respect to the collector rotation direction (45, 90° or others). The obtained results demonstrated that the mats cut in the collector rotation direction (0°) display better mechanical properties compared to those cut at an angle of 90°. Therefore, in the present study, we have performed the mechanical testing of membranes cut in the collector rotation direction. The measurement of the mechanical strength of the obtained membranes showed that CA membranes had the highest values of tensile strength. However, the detected values for the tensile strength and Young’s modulus of the CA nanofibrous membranes were relatively low. This is most probably caused by the semirigid backbone structure of cellulose acetate and due to the fact that the fibers are loosely packed together. It was found that the incorporation of 5-Cl8Q does not alter the mechanical properties of the membranes. However, the incorporation of low-molecular-weight PEG resulted in a decrease of the tensile strength of the membranes. The observed decrease in mechanical properties is in good agreement with the results of Chen et al. [
32], who reported lower values regarding the ultimate strength and ultimate strain of all the composite CA/PEG fibers compared to those of CA fibers. They have assumed that the decrease of the mechanical properties of the PEG/CA composite fibers was due to the introduction of PEG, which broke the continuous phase structure of CA. Therefore, the addition of PEG had an unfavorable effect on the tensile properties of the composite fibers. We succeeded in obviating this effect to some extent by using high-molecular-weight polyoxyethylene (MW 100,000) instead of PEG
2000.
Experiments to determine the release behavior of the bioactive compound from the obtained membranes were performed. The greatest extent of release of 5-Cl8Q was from the CA/PEG/5-Cl8Q membrane. We supposed that the facilitated 5-Cl8Q release was due to the presence of the water-soluble polymer PEG in the polymer membrane.
8-Hydroxyquinoline derivatives display a broad range of biological activities, including antifungal activity against pathogenic fungi causing diseases in humans and in animals [
33]. The low MIC values of 5-Cl8Q determined by us against
P. chlamydospora and
P. aleophilum [
12] give us reason to expect that the incorporation of 5-Cl8Q in fibrous membranes will result in efficient antifungal membranes. Because of the growth characteristics of
P. chlamydospora and
P. aleophilum fungi, their development was followed for 96 h. All the membranes containing 5-Cl8Q completely inhibited fungal growth within 96 h; this is due to the fact that the 5-Cl8Q content in the membranes was much higher than the determined MIC of 5-Cl8Q, and, in addition, the release profile of 5-Cl8Q provided sufficient even in the early stages of the experiments.